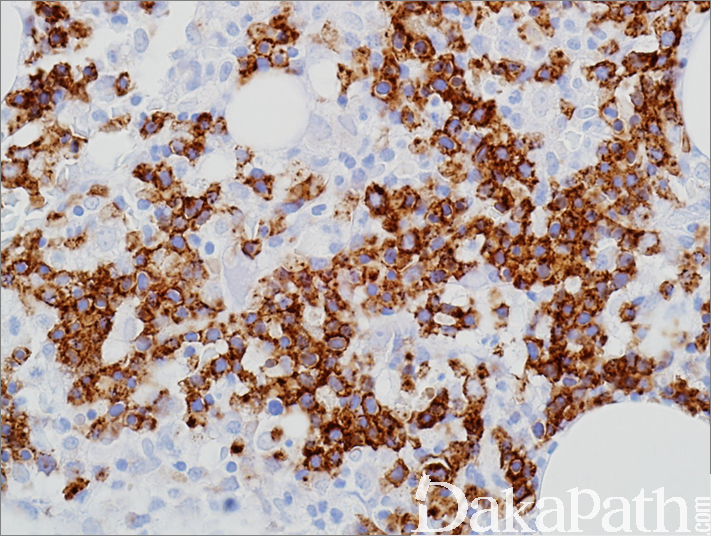

CD71
别名: transferrin receptor;TfR;转铁蛋白受体
概述:
CD71 是与细胞的成熟、增殖、分化密切相关的分子,在许多类型的细胞表面均有表达。常用于在骨髓样本中标记红系前体细胞。
信号定位: 胞膜/胞质
在病理学中的应用:
常用于骨髓样本中观察红系前体细胞。
商品化试剂(排名不分先后,本网站对抗体质量不负责!)
公司 | 克隆号 | 即用型(ml) | 原液(ml) | ||||
基因科技 | 10F11 | / | 2 | 4 | 7 | / | 0.2 |
赛诺特 | MRQ-48 | 1 | 3 | 6 | / | 0.1 | 0.2 |
安必平 | MRQ-48 | 1.5 | 3 | 6 | / | 0.1 | 0.2 |
在肿瘤中的表达情况:
几乎全部阳性(≥95%的病例阳性): 急性髓系白血病,NOS、弥漫大 B 型大 B 细胞淋巴瘤,非特指型、T 淋巴母细胞白血病/淋巴瘤、滤泡性淋巴瘤、B 淋巴母细胞白血病/淋巴瘤、慢性髓系白血病、边缘区 B 细胞淋巴瘤、套细胞淋巴瘤、浆细胞骨髓瘤、慢性粒-单核白血病、慢性淋巴细胞白血病/B 小淋巴细胞淋巴瘤